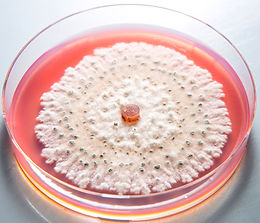

2015

EST

S Media
2
Food for Bugs - Not People or Pets™

Our Story...
S2Media is a certified woman owned small business located in Spokane Valley, WA. Uniquely located in the Pacific Northwest, we provide high quality products throughout North America.
Our leadership team has over 50 years of combined industry experience. Our expertise includes aseptic processes, manufacturing, quality assurance, quality control, and supply chain.
Our facility is registered with the FDA and many of our products are compliant with published standards including USP, EPA, AOAC, and CLSI. We manufacture cGMP compliant products and can customize products to meet your needs.


"A satisfied customer is the best business strategy."
Michael LeBoeuf | Author
"We all need people who will give us feedback. That's how we improve."
Bill Gates, Founder | Microsoft


Lab Coordinator
& Instructor,
Gonzaga University
S2Media has been fantastic about catering to our needs in product and numbers. Their service is excellent and the quality the best in our area! I'd be happy to talk to other education
institutions or research labs about our experience with S2M. They are awesome!

Account Manager,
Cole Diagnostics
I am so glad to work with S2Media! The team at S2M is extremely knowledgeable and no one else offers the excellent customer service that they do!

Laboratory Supervisor,
LabCor, Incorporated
Our lab has been a client of S2Media for the past several years and continue to rely on them for a majority of our specialty media needs. All micro labs know that once an "in-house" media has been tailored, it can seldom be beat. Not the case with S2M. Our decision to use them came after we witnessed a 42% increase in PT recoveries over our traditional in-house media. I wish all companies executed orders with the efficiency, speed and accuracy as S2M. Impeccable customer service. Thank you S2Media!
Clinical Microbiology Technical Specialist, Providence SHMC
We have called upon S2Media to produce custom products for us that were not available from other media vendors. S2M has not only demonstrated the ability to fulfill our requests, but they have the technical expertise to fine-tune those products until they work perfectly. S2M has provided high quality products and excellent customer service to us.